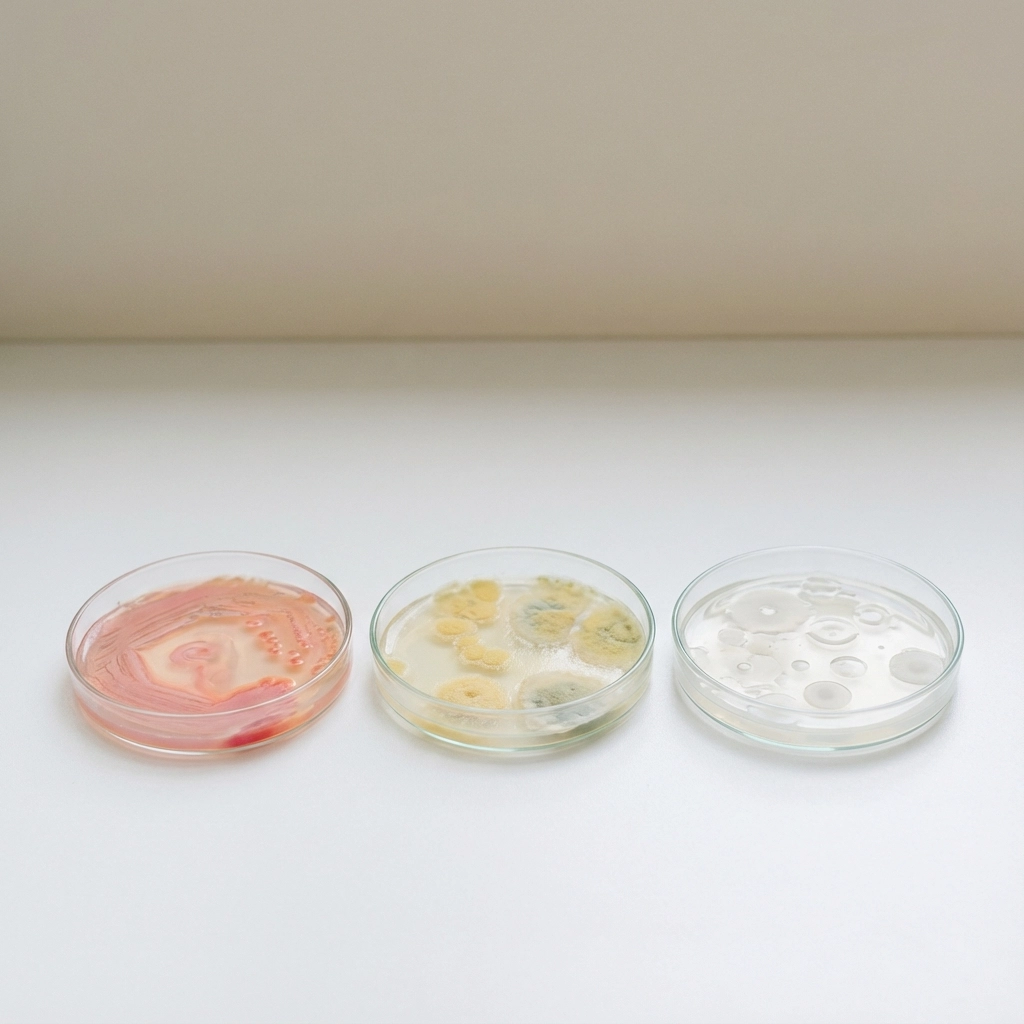
image_2

Understanding how climate affects skin isn’t just about weather forecasts: it’s about predicting your customers’ skincare needs before they even know they have them. For Australian beauty brands, this knowledge is your competitive edge in a market where climate diversity spans from tropical Queensland to temperate Tasmania.
The relationship between environment and skin health is more complex than most brands realise. It’s not simply about hot weather making skin oily or cold weather causing dryness. Climate impacts everything from your skin’s microbiome to its aging process, and these effects are intensifying as our environment continues to change.
How Different Australian Climates Affect Skin
Australia’s diverse climate zones create distinct skincare challenges that savvy brands can address with targeted solutions.
Hot and Humid Coastal Regions
In coastal areas like Brisbane, Sydney, and Darwin, excess moisture in the air creates a perfect storm for skin issues. The high humidity increases oil production, particularly in the T-zone, while sweat buildup leads to clogged pores and breakouts on the forehead, back, and chest. Your customers in these regions are dealing with:
- Increased sebum production
- Bacterial overgrowth from trapped moisture
- Heat rash and irritation from sweat
- Difficulty with product absorption due to high humidity
Hot and Dry Inland Areas
Central and western Australia’s arid conditions pull moisture directly from the skin. UV exposure is typically stronger in these environments, creating a double challenge of dehydration and sun damage. Customers experience:
- Rough, flaking skin patches
- Increased sensitivity and irritation
- Accelerated photo-aging
- Compromised skin barrier function
Cooler Southern Regions
Melbourne, Adelaide, and Hobart’s variable climate brings its own set of challenges. Cold, dry conditions worsen sensitivity and exacerbate inflammatory conditions like rosacea and eczema. Indoor heating further reduces ambient moisture, creating year-round hydration challenges.
The Science Behind Climate-Driven Skin Changes
Beyond the obvious effects of sun and wind, climate influences skin health through several sophisticated pathways that forward-thinking brands must understand.
Thermal Aging: The Hidden Threat
Infrared radiation from heat exposure contributes to thermal aging: a process where sustained heat compromises collagen and elastin fibres. This leads to:
- Fine lines and wrinkles appearing earlier
- Loss of skin firmness and elasticity
- Uneven skin tone and texture
- Increased melanin production causing dark spots
This is particularly relevant for Australian brands, where high temperatures and strong sun exposure accelerate these processes year-round.
Microbiome Disruption
Rising temperatures directly disrupt the skin microbiome, affecting conditions like:
- Atopic dermatitis
- Acne vulgaris
- Psoriasis
- General skin sensitivity
The delicate balance of beneficial bacteria on our skin becomes unstable with temperature fluctuations, creating opportunities for harmful bacteria to flourish.
Air Quality and Pollution Effects
Australia’s bushfire seasons and urban pollution create additional skin stressors. Airborne particles and smoke correlate with increased dermatitis and eczema clinic visits. These environmental factors cause:
- Oxidative stress on skin cells
- Inflammatory responses
- Accelerated aging
- Barrier function compromise
Emerging Skin Challenges from Climate Change
Climate change is creating new skincare challenges that Australian brands must anticipate and address.
Extended Allergy Seasons
Warmer temperatures extend pollen seasons and make plants more potent allergens. Higher carbon dioxide levels increase the severity of plant-based skin reactions, leading to more frequent and severe contact dermatitis.
Vector-Borne Skin Issues
Changing climate patterns are expanding the geographic range of disease-carrying insects. Warmer temperatures at higher latitudes make previously temperate areas hospitable to mosquitoes and other vectors, increasing the risk of insect-related skin problems.
Stress-Related Skin Conditions
Climate-related stress from natural disasters, extreme weather events, and environmental changes can trigger or worsen:
- Psoriasis flares
- Dermatitis outbreaks
- Stress-induced hair loss
- Vitiligo progression
- Chronic hives
What This Means for Australian Beauty Brands
This climate-skin connection presents both challenges and opportunities for Australian beauty manufacturers. Understanding these patterns allows you to develop targeted solutions that address real, science-backed customer needs.
Regional Product Differentiation
Australia’s climate diversity creates natural market segments. Instead of one-size-fits-all formulations, consider developing:
- Humid climate collections for coastal customers
- Arid environment solutions for inland markets
- Transition formulas for areas with variable weather patterns
Preventative Formulation Focus
Rather than simply treating existing skin problems, climate-conscious brands can prevent issues before they start. This approach positions your products as sophisticated, science-backed solutions rather than basic remedies.
Seasonal Adaptation Strategies
Australian seasons create predictable skin care needs. Brands that anticipate and address these seasonal shifts demonstrate deep understanding of their customers’ experiences.
Practical Strategies for Climate-Conscious Formulation
Transform this climate knowledge into actionable product development strategies that differentiate your brand in the marketplace.
Microbiome Support Ingredients
Incorporate prebiotics and probiotics that support healthy skin bacteria, especially important as temperature fluctuations disrupt natural balance. Key ingredients include:
- Lactobacillus ferment
- Bifida ferment lysate
- Inulin and fructooligosaccharides
- Alpha-glucan oligosaccharides
Anti-Pollution Protection
Develop formulations that protect against environmental pollutants increasingly common in Australian cities and bushfire-affected areas:
- Antioxidant complexes (vitamin C, E, ferulic acid)
- Barrier-strengthening ceramides
- Anti-inflammatory botanicals
- Detoxifying clays and charcoals
Thermal Protection Technology
Address thermal aging with ingredients that protect against infrared radiation:
- Zinc oxide and titanium dioxide for broad-spectrum protection
- Antioxidants that neutralise heat-generated free radicals
- Peptides that support collagen synthesis
- Cooling botanicals like aloe and cucumber
Adaptive Hydration Systems
Create formulations that adjust to environmental humidity levels:
- Hyaluronic acid in multiple molecular weights
- Smart delivery systems that release moisture as needed
- Humectants that draw moisture from the environment when available
- Occlusives that prevent water loss in dry conditions
Stress-Response Ingredients
Include ingredients that help skin cope with climate-related stress:
- Adaptogenic botanicals like ashwagandha and ginseng
- Niacinamide for inflammation control
- Chamomile and centella for calming effects
- Peptides that support skin repair processes
Future-Proofing Your Product Line
Climate patterns will continue evolving, making adaptability a crucial brand characteristic. Consider developing modular product systems that customers can customise based on current environmental conditions.
Concentration Adjustments
Offer the same active ingredients in different concentrations for varying climate needs. A vitamin C serum might come in 10% strength for sensitive, cool weather and 20% strength for high-pollution, high-stress environments.
Seasonal Limited Editions
Create anticipation and relevance with seasonal formulations that address specific climate challenges. A “Bushfire Season” protective serum or “Humid Summer” lightweight moisturiser demonstrates responsive brand thinking.
Educational Content Integration
Position your brand as the climate-skin expert by providing educational content alongside products. Help customers understand not just what to use, but why environmental factors make certain ingredients necessary.
The intersection of climate science and skincare represents an enormous opportunity for Australian beauty brands willing to dig deeper than surface-level trends. By understanding how environmental factors truly affect skin health, you can develop products that solve real problems before your customers even recognise them.
Climate-conscious formulation isn’t just about following trends: it’s about demonstrating genuine expertise in the complex relationship between environment and skin health. Australian brands that master this relationship will find themselves uniquely positioned to serve an increasingly climate-aware consumer base.
Ready to transform your understanding of climate effects into market-leading formulations? The science is clear, the opportunity is immense, and your customers are waiting for brands that truly understand their environmental challenges.
post comments
Read more like this